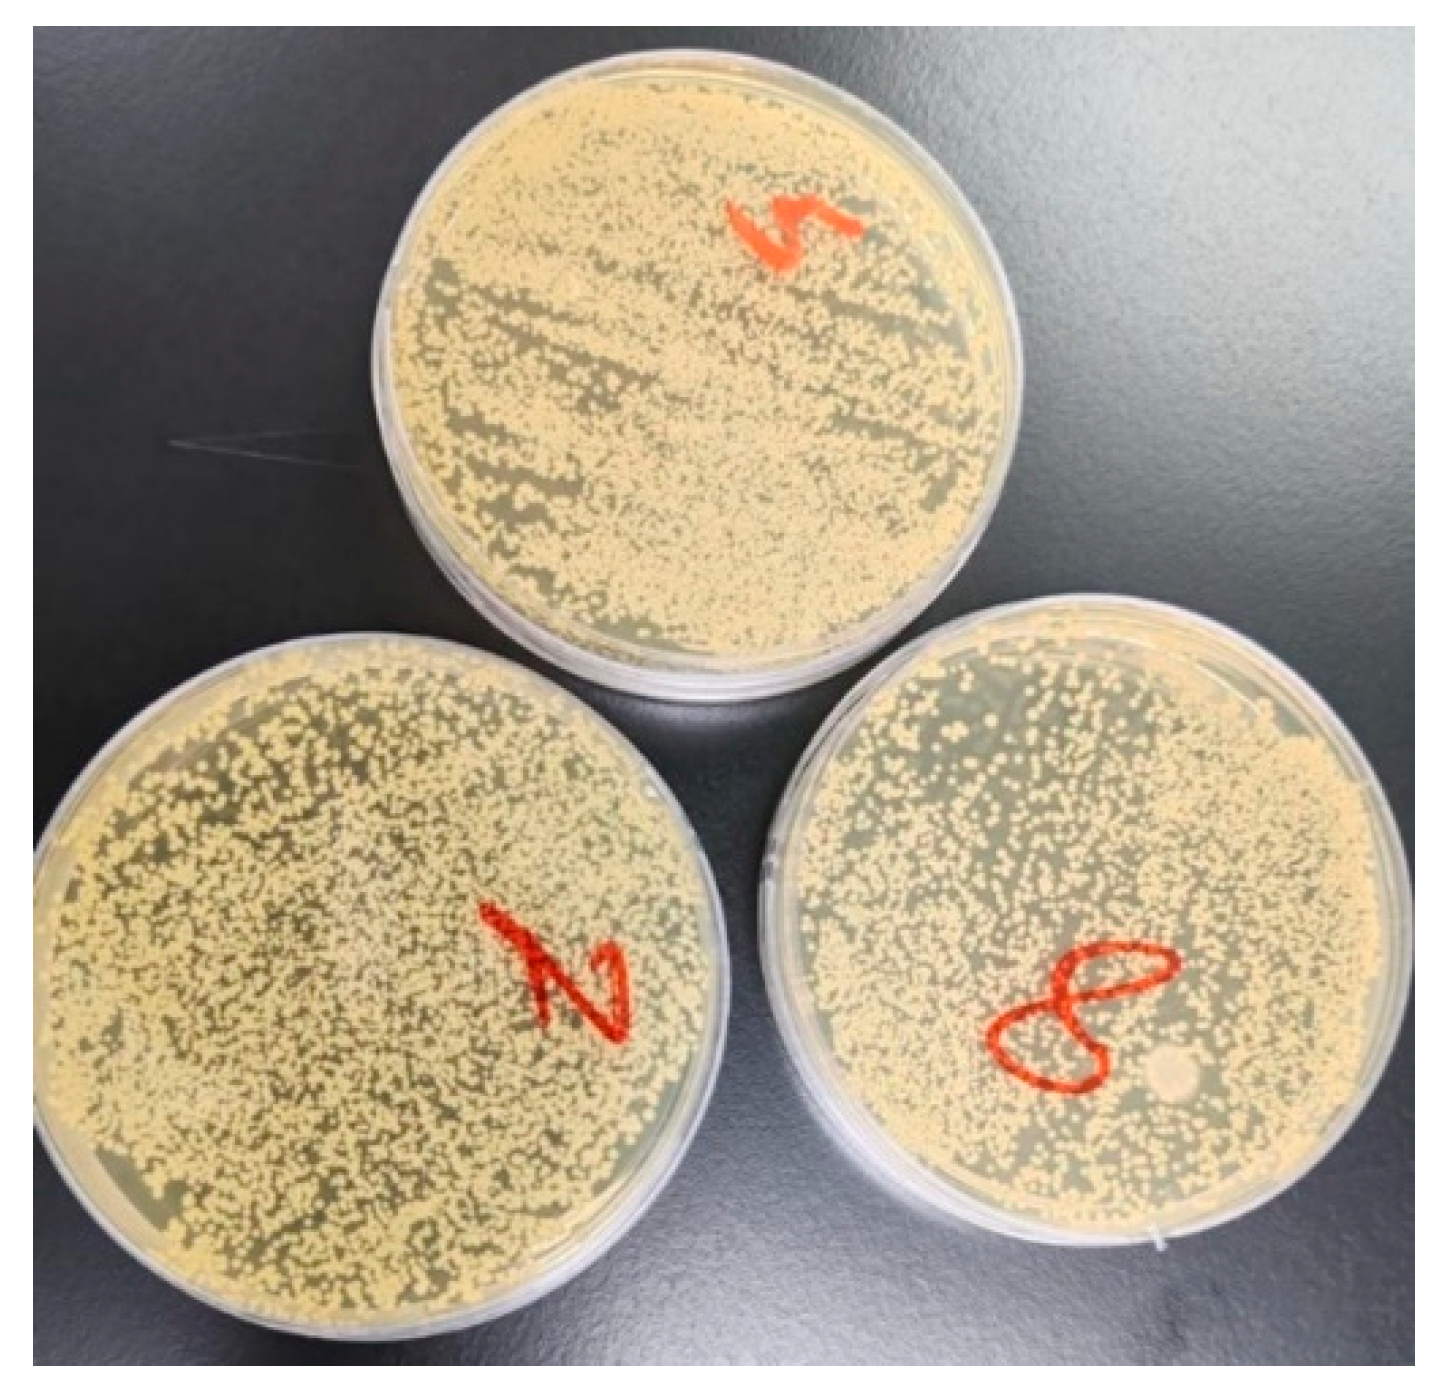

Comparative Analysis of the Effects of Acidic and Alkaline Beverages on the Optical Properties, Surface Topography, and Bacterial Activity of Zirconia Materials
Abstract
1. Introduction
2. Materials and Methods
2.1. Study Design and Sample Size Calculation
2.2. Specimen Manufacturing
2.3. pH Measurement
2.4. Sample Grouping
2.5. Color Parameter Measurements
2.6. Staining of Glazed Zirconia Circular Discs
2.7. Surface Roughness Measurements
2.8. Bacterial Adhesion Analysis
2.9. SEM for Surface Topography Assessment
2.10. Statistical Analysis
3. Results
3.1. pH Values
3.2. Mean Values of the Color Parameter Changes
3.3. Mean Color Change, Surface Roughness, and Bacterial Adhesion
3.4. Scanning Electron Microscopic Results
4. Discussion
5. Conclusions
Funding
Institutional Review Board Statement
Informed Consent Statement
Data Availability Statement
Conflicts of Interest
Abbreviations
| ΔE* | Mean color change |
| Ra | Surface roughness |
| CFUs | Colony-forming units |
| S. mutans | Streptococcus mutans |
References
- Chopra, D.; Guo, T.; Gulati, K.; Ivanovski, S. Load, unload and repeat: Understanding the mechanical characteristics of zirconia in dentistry. Dent. Mater. 2024, 40, e1–e17. [Google Scholar] [CrossRef]
- Zarone, F.; Di Mauro, M.I.; Ausiello, P.; Ruggiero, G.; Sorrentino, R. Current status on lithium disilicate and zirconia: A narrative review. BMC Oral. Health 2019, 19, 134. [Google Scholar] [CrossRef]
- Bülbül, M.; Palta, N.; Erdinç, G. Effect of Aging Procedures on Phase Transformation of Posterior 3-Unit Zirconia Frameworks Used in Fixed Partial Dentures. Niger. J. Clin. Pract. 2025, 28, 188–194. [Google Scholar] [CrossRef]
- Okkar Kyaw Inokoshi, M.; Kanazawa, M. Tribological aspects of enamel wear caused by zirconia and lithium disilicate: A meta-narrative review. JPN Dent. Sci. Rev. 2024, 60, 258–270. [Google Scholar] [CrossRef] [PubMed]
- Yerliyurt, K.; Sarıkaya, I. Color stability of hybrid ceramics exposed to beverages in different combinations. BMC Oral. Health 2022, 22, 180. [Google Scholar] [CrossRef]
- Lehrkinder, A.; Rydholm, O.; Wänström, A.; Nakamura, K.; Örtengren, U. The formation of cariogenic plaque to contemporary adhesive restorative materials: An in vitro study. Odontology 2024, 112, 1090–1102. [Google Scholar] [CrossRef]
- Esquivel-Upshaw, J.F.; Dieng, F.Y.; Clark, A.E.; Neal, D.; Anusavice, K.J. Surface degradation of dental ceramics as a function of environmental pH. J. Dent. Res. 2013, 92, 467–471. [Google Scholar] [CrossRef]
- Pandoleon, P.; Kontonasaki, E.; Kantiranis, N.; Pliatsikas, N.; Patsalas, P.; Papadopoulou, L.; Zorba, T.; Paraskevopoulos, K.M.; Koidis, P. Aging of 3Y-TZP dental zirconia and yttrium depletion. Dent. Mater. 2017, 33, e385–e392. [Google Scholar] [CrossRef]
- Hsu, S.M.; Ren, F.; Batich, C.D.; Clark, A.E.; Neal, D.; Esquivel-Upshaw, J.F. Effect of pH Cycling Frequency on Glass-Ceramic Corrosion. Materials 2020, 13, 3655. [Google Scholar] [CrossRef] [PubMed]
- Farhadi, E.; Kermanshah, H.; Rafizadeh, S.; Saeedi, R.; Ranjbar Omrani, L. In Vitro Effect of Acidic Solutions and Sodium Fluoride on Surface Roughness of Two Types of CAD-CAM Dental Ceramics. Int. J. Dent. 2021, 2021, 9977993. [Google Scholar] [CrossRef] [PubMed]
- Adawi, H.A.; Al Mialeem, M.M.; Al Ahmari, N.M.; Shariff, M.; Qahhar, M.A.; Muharraq, S.M.H.; Alghazali, N.A. Assessment of Color Stainability of Computer-Aided Design and Computer-Aided Manufacturing (CAD/CAM) Ceramic Materials After Hot and Cold Coffee Immersion at Different Time Intervals. Med. Sci. Monit. 2021, 27, e932745. [Google Scholar] [CrossRef] [PubMed]
- Podgórski, F.; Musyt, W.; Nijakowski, K. The impact of sports drink exposure on the surface roughness of restorative materials: A systematic review. J. Compos. Sci. 2025, 9, 234. [Google Scholar] [CrossRef]
- CIE. Colorimetry, 4th ed.; CIE 015:2018; International Commission on Illumination (CIE): Vienna, Austria, 2018; ISBN 978-3-902842-13-8. [Google Scholar] [CrossRef]
- Ly, B.; Dyer, E.; Feig, J.; Chien, A.; Bino, S. Research Techniques Made Simple: Cutaneous Colorimetry: A Reliable Technique for Objective Skin Color Measurement. J. Investig. Dermatol. 2020, 140, 3–12.e1. [Google Scholar] [CrossRef] [PubMed]
- Daghrery, A.; Khayat, W.; Albar, N.; Khojah, M.; Jabarti, E.; Mitwalli, H.; Al Moaleem, M. Impact of common social habits on optical properties of lithium disilicate glass ceramic crowns: An in vitro study. Heliyon 2024, 10, e34172. [Google Scholar] [CrossRef]
- Al Moaleem, M.M.; Adawi, H.A.; Alsharif, K.F.; Alhazmi, H.A.; Alshahrani, F.A.; Abu Hadi, R.M.; Kara, R.; Muyidi, H.M.; Khalid, A.; Asiri, A.M.; et al. Impact of Smokeless Tobacco on the Color Stability of Zirconia, Zirconia-Reinforced Lithium Silicate and Feldspathic CAD/CAM Restorative Materials: An In-Vitro Study. Coatings 2022, 12, 207. [Google Scholar] [CrossRef]
- Alrabeah, G.; Habib, S.R.; Alamro, N.M.; Alzaaqi, M.A. Evaluation of the effect of electronic cigarette devices/vape on the color of dental ceramics: An in vitro investigation. Materials 2023, 16, 3977. [Google Scholar] [CrossRef]
- Alghazali, N.; Burnside, G.; Moallem, M.; Smith, P.; Preston, A.; Jarad, F.D. Assessment of perceptibility and acceptability of color difference of denture teeth. J. Dent. 2012, 40 (Suppl. S1), e10–e17. [Google Scholar] [CrossRef]
- Al-Haj Husain, N.; Dürr, T.; Özcan, M.; Brägger, U.; Joda, T. Mechanical stability of dental CAD-CAM restoration materials made of monolithic zirconia, lithium disilicate, and lithium disilicate-strengthened aluminosilicate glass-ceramic with and without fatigue conditions. J. Prosthet. Dent. 2022, 128, 73–78. [Google Scholar] [CrossRef]
- Prajapati, A.M.; Sanyal, P.K.; Guru, R.; Vaswani, P.; Tewary, S.; Sushma, R. Effect of tobacco extract, cigarette smoke, and carbonated beverage on surface roughness and color stability of three different restorative materials: An in vitro study. Int. J. Prev. Clin. Dent. Res. 2017, 4, 9–18. [Google Scholar] [CrossRef]
- Tanthanuch, S.; Kukiattrakoon, B.; Thongsroi, T.; Saesaw, P.; Pongpaiboon, N.; Saewong, S. In vitro surface and color changes of tooth-colored restorative materials after sport and energy drink cyclic immersions. BMC Oral Health 2022, 22, 578. [Google Scholar] [CrossRef]
- Al Moaleem, M.M.; AlSanosy, R.; Ahmari, N.M.A.; Shariff, M.; Alshadidi, A.A.; Alhazmi, H.A.; Khalid, A. Effects of Khat on Surface Roughness and Color of Feldspathic and Zirconia Porcelain Materials under Simulated Oral Cavity Conditions. Medicina 2020, 56, 234. [Google Scholar] [CrossRef]
- Moaleem, M.M.A.; Alamoudi, M.S.M.; Aldhahri, G.F.; Alzaylaei, A.R.; Daoud, O.Z.M.; Hummadi, A.M.; Hakami, H.I.; Marran, K.M.; Omair, H.A.; Hakami, A.M. Color changes of ceramic materials used for inlay and veneers restorations after staining with different time intervals. J. Pharm. Res. Int. 2021, 33, 46–56. [Google Scholar] [CrossRef]
- Alzahrani, A.H.; Aldosari, L.I.N.; Alshadidi, A.A.F.; Al Moaleem, M.M.; Dhamiri, R.A.A.; Aldossary, M.B.F.; Hazazi, Y.Y.; Awaji, F.A.M.; Ageeli, A.M. Influence of Surface Type with Coffee Immersion on Surface Topography and Optical and Mechanical Properties of Selected Ceramic Materials. Med. Sci. Monit. 2022, 28, e938354. [Google Scholar] [CrossRef]
- Tu, Y.; Ren, H.; He, Y.; Ying, J.; Chen, Y. Interaction between microorganisms and dental material surfaces: General concepts and research progress. J. Oral Microbiol. 2023, 15, 2196897. [Google Scholar] [CrossRef] [PubMed]
- Monteiro, D.R.; de Souza Batista, V.E.; Caldeirão, A.C.M.; Jacinto, R.d.C.; Pessan, J.P. Oral prosthetic microbiology: Aspects related to the oral microbiome, surface properties, and strategies for controlling biofilms. Biofouling 2021, 37, 353–371. [Google Scholar] [CrossRef] [PubMed]
- Hao, Y.; Huang, X.; Zhou, X.; Li, M.; Ren, B.; Peng, X.; Cheng, L. Influence of Dental Prosthesis and Restorative Materials Interface on Oral Biofilms. Int. J. Mol. Sci. 2018, 19, 3157. [Google Scholar] [CrossRef] [PubMed]
- Abdalkadeer, H.K.; Almarshedy, S.M.; Al Ahmari, N.M.; Al Moaleem, A.M.; Aldosari, A.A.; Al Ghazali, N.A. Influence of the Coca-Cola Drinks on the Overall Color of Glazed or Polished Porcelain Veneers Fabricated from Different Materials and Thicknesses: An In Vitro Study. J. Contemp. Dent. Pract. 2020, 21, 56–61. [Google Scholar] [CrossRef]
- Aldosari, L.I.; Alshadidi, A.A.; Porwal, A.; Al Ahmari, N.M.; Al Moaleem, M.M.; Suhluli, A.M.; Shariff, M.; Shami, A.O. Surface roughness and color measurements of glazed or polished hybrid, feldspathic, and Zirconia CAD/CAM restorative materials after hot and cold coffee immersion. BMC Oral Health 2021, 21, 422. [Google Scholar] [CrossRef]
- Mosallam, R.; Taymour, M.; Katamish, H.; Kheirallah, L. Clinical assessment of color stability and patient satisfaction for polished versus glazed lithium disilicate glass ceramic restorations: Randomized controlled clinical trial. Int. J. Health Sci. 2022, 6, 2819–2830. [Google Scholar] [CrossRef]
- Bislimi, F.; Bajevska, G.; Garai, M.; Reka, A.A. A study on the bacterial adhesion of Streptococcus mutans in various dental ceramics: In vitro study. Open Chem. 2020, 18, 1334–1338. [Google Scholar] [CrossRef]
- Engel, A.S.; Kranz, H.T.; Schneider, M.; Tietze, J.P.; Piwowarcyk, A.; Kuzius, T.; Arnold, W.; Naumova, E.A. Biofilm formation on different dental restorative materials in the oral cavity. BMC Oral Health 2020, 20, 162. [Google Scholar] [CrossRef]
- Tu, Y.; Deng, S.; Wang, Y.; Lin, X.; Yang, Z. Adhesive Ability of Different Oral Pathogens to Various Dental Materials: An In Vitro Study. Can. J. Infect. Dis. Med. Microbiol. 2022, 2022, 9595067. [Google Scholar] [CrossRef]
- Vulović, S.; Todorović, A.; Toljić, B.; Nikolić-Jakoba, N.; Tovilović, T.V.; Milić-Lemić, A. Evaluation of early bacterial adhesion on CAD/CAM dental materials: An in situ study. Odontology. 2025, 113, 101–110. [Google Scholar] [CrossRef]
- Chenicheri, S.; Usha, R.; Ramachandran, R.; Thomas, V.; Wood, A. Insight into Oral Biofilm: Primary, Secondary and Residual Caries and Phyto-Challenged Solutions. Open Dent. J. 2017, 11, 312–333. [Google Scholar] [CrossRef] [PubMed]
- Duymus, Z.; Ozdogan, A.; Ulu, H. Effect of Different Acidic Agents on Surface Roughness of Feldspathic Porcelain. Open J. Stom. 2016, 6, 90–95. [Google Scholar] [CrossRef][Green Version]
- Al-Thobity, A.M.; Gad, M.M.; Farooq, I.; Alshahrani, A.S.; Al-Dulaijan, Y.A. Acid Effects on the Physical Properties of Different CAD/CAM Ceramic Materials: An in Vitro Analysis. J. Prosthodont. 2021, 30, 135–141. [Google Scholar] [CrossRef] [PubMed]
- ISO 25178-2:2021; Geometrical Product Specifications—Surface Texture: Areal—Part 2: Terms Definitions Surface Texture Parameters. ISO: Geneva, Switzerland, 2021.
- Khoury, P.; Kharouf, N.; Etienne, O.; Dillenseger, J.P.; Haikel, Y.; El-Damanhoury, H.M.; Irani, D.; Ozcan, M.; Salameh, Z. Physicochemical Properties and Bacterial Adhesion of Conventional and 3D Printed Complete Denture PMMA Materials: An In Vitro Study—Part I. J. Contemp. Dent. Pract. 2024, 25, 1001–1008. [Google Scholar]
- Tarrosh, M.Y. Effect of Axial Wall Height on Bacterial Adhesion, Marginal Seal, and Color Change of One-piece Molar Zirconia Endocrown. J. Contemp. Dent. Pract. 2025, 26, 303–310. [Google Scholar] [CrossRef]
- Lolos, D.; Mihali, S.G.; Dinu, S.; Mitariu, M.; Tudor, A.; Oancea, R. Retrospective Long-Term Survival Rate and Clinical Performance of Zirconium Oxide Restorations over the Past 5 Years: A Comparative Study Between Single Crowns and Fixed Dental Prostheses. Medicina 2025, 61, 210. [Google Scholar] [CrossRef] [PubMed]
- Al Moaleem, M.M.; Al Ahmari, N.M. Clinical and Radiographical Evaluation of Endocrowns Fabricated from Different CAD/CAM Ceramic Materials. Ceram.-Silikáty 2024, 68, 471–480. [Google Scholar] [CrossRef]
- Alshehri, A.H.; Al Moaleem, M.M. Effect of social habits on the clinical performance of CAD/CAM ceramic prosthesis fabricated from different ceramic materials: 12-month follow-up. Open Dent. J. 2025, 19, e18742106366982. [Google Scholar] [CrossRef]
- Haralur, S.B.; Raqe SAlqahtani, N.; Alhassan Mujayri, F. Effect of Hydrothermal Aging and Beverages on Color Stability of Lithium Disilicate and Zirconia Based Ceramics. Medicina 2019, 55, 749. [Google Scholar] [CrossRef]
- Mugri, M.H.; Jain, S.; Sayed, M.E.; Halawi, A.H.A.; Hamzi, S.A.I.; Aljohani, R.A.S.; Madkhali, Z.M.A.; Khalid, A.; Jokhadar, H.F.; Almarzouki, M.; et al. Effects of Smokeless Tobacco on Color Stability and Surface Roughness of 3D-Printed, CAD/CAM-Milled, and Conventional Denture Base Materials: An In Vitro Study. Biomedicines 2023, 11, 491. [Google Scholar] [CrossRef]
- Alnasser, H.A.; Elhejazi, A.A.; Al-Abdulaziz, A.A.; Alajlan, S.S.; Habib, S.R. Effect of Conventional and Electronic Cigarettes Smoking on the Color Stability and Translucency of Tooth Colored Restorative Materials: An In Vitro Analysis. Coatings 2021, 11, 1568. [Google Scholar] [CrossRef]
- Alnasser, M.; Finkelman, M.; Papathanasiou, A.; Suzuki, M.; Ghaffari, R.; Ali, A. Effect of acidic pH on surface roughness of esthetic dental materials. J. Prosthet. Dent. 2019, 122, e1–e567. [Google Scholar] [CrossRef] [PubMed]
- Özer, N.E.; Oğuz, E.İ. Evaluation of the Clinical Success of Fissure Sealants Applied to Young Permanent Teeth. NEU Dent. J. 2025, 7, 9–18. [Google Scholar] [CrossRef]
- Alqahtani, A.; AlHelal, A.A.; Albani, R.; Ali, M.; Badghshar, O.A.O.; Khan, A.S.; Habib, S.R. Effect of cigarette smoking on the optical properties of contemporary dental ceramics: An in-vitro analysis. PeerJ 2024, 12, e18564. [Google Scholar] [CrossRef]
- Zhang, C.Y.; Agingu, C.; Tsoi, J.K.H.; Yu, H. Effects of Aging on the Color and Translucency of Monolithic Translucent Y-TZP Ceramics: A Systematic Review and Meta-Analysis of In Vitro Studies. Biomed. Res. Int. 2021, 2021, 8875023. [Google Scholar] [CrossRef]
- Kukiattrakoon, B.; Hengtrakool, C.; Kedjarune-Leggat, U. Effect of acidic agents on surface roughness of dental ceramics. Dent. Res. J. 2011, 8, 6–15. [Google Scholar]
- Hussein, R.F.; Mohammed, H.R.; Haggag, K.M. Effect of various pH media on some optical properties and surface roughness of bilayered reinforced polymer and monolithic hybrid ceramic (An in-vitro study). Al-Azhar J. Dent. Sci. 2020, 23, 255–262. [Google Scholar] [CrossRef]
- Kreve, S.; Dos Reis, A.C. Effect of surface properties of ceramic materials on bacterial adhesion: A systematic review. J. Esthet. Restor. Dent. 2022, 34, 461–472. [Google Scholar] [CrossRef]
- Alghazali, N.; Hakami, A.A.; AlAjlan, G.A.; Alotaibi, R.M.; Alabdulwahab, F.N.; AlQuraishi, L.A.; Abdalkadeer, H.; Al Moaleem, M.A. Influence of the Arabic-coffee on the overall color of glazed or polished porcelain veneers-study. Open Dent. J. 2019, 13, 364–370. [Google Scholar] [CrossRef]
- Al-Ahmari, M.M.; Alzahrani, A.H.; Al-Qatarneh, F.A.; Al Moaleem, M.M.; Shariff, M.; Alqahtani, S.M.; Porwal, A.; Al-Sanabani, F.A.; AlDhelai, T.A. Effect of Miswak Derivatives on Color Changes and Mechanical Properties of Polymer-Based Computer-Aided Design and Computer-Aided Manufactured (CAD/CAM) Dental Ceramic Materials. Med. Sci. Monit. 2022, 28, e936892. [Google Scholar] [CrossRef] [PubMed]
- Şişmanoğlu, S.; Gürcan, A.T. Evaluation of stain susceptibility of different CAD/CAM blocks after immersion in coffee. Düzce Üniversitesi Sağlık Bilim. Enstitüsü Derg. 2021, 11, 284–289. [Google Scholar] [CrossRef]
- Pérez, M.M.; Carrillo-Perez, F.; Tejada-Casado, M.; Ruiz-López, J.; Benavides-Reyes, C.; Herrera, L.J. CIEDE2000 lightness, chroma and hue human gingiva thresholds. J. Dent. 2022, 124, 104213. [Google Scholar] [CrossRef]
- Tejada-Casado, M.; Herrera, L.J.; Carrillo-Perez, F.; Ruiz-López, J.; Ghinea, R.I.; Pérez, M.M. Exploring the CIEDE2000 thresholds for lightness, chroma, and hue differences in dentistry. J. Dent. 2024, 150, 105327. [Google Scholar] [CrossRef]

| Material/Device Type | Brand Name/pH | Composition/Description | Manufacturer | Color/Application Per Day |
|---|---|---|---|---|
| Zircon CAD/CAM | Ceramill Zolid multilayer PS | ZrO2 + HfO2 + Y2O3: ≥99.0, Y2O3: 8.5–9.5, HfO2: ≤5, Al2O3: ≤0.5, other oxides: ≤1 | Amann Girrbach, Germany | B1 Light |
| pH meter device | PHS-1705 Benchtop pH Meter | Investigational glass test tube of the pH device with a pen and a digital screen displaying the values of pH | Shanghai BOQU Instrument Co., Ltd. | -- |
| Mirinda | Mirinda Citrus carbonated soft drink/pH value of 3.23 (acidic) | Carbonated water, sugar, concentrated orange juice, citric acid, natural citrus flavor, caffeine, sodium benzoate (preservative), sodium citrate (acidity regulator), acacia gum (emulsifier), ascorbic acid, calcium-disodium EDTA (antioxidants), and color tartrazine (E102) | National Carbonated Beverages Co., Ltd. (PepsiCo KSA) | Bright yellow-green/two |
| CodeRed | Mountain Dew Code Red—cherry–citrus flavor/pH value of 3.34 (acidic) | Carbonated water, high-fructose corn syrup, concentrated orange juice, citric acid, sodium polyphosphates, sodium benzoate, natural flavor, caffeine, sodium citrate, Arabic gum, calcium-disodium EDTA, Red 40, Yellow 5, Blue 1 | PepsiCo Beverages North America | Deep red/two |
| Yerba mate tea | ENVASADA ENORIGEN TARAGUI/pH value of 5.27 (acidic) | Caffeic acid, caffeine, caffeoyl derivatives, caffeoylshikimic acid, chlorogenic acid, feruloylquinic acid, kaempferol, quercetin, quinic acid, rutin, and theobromine | INDUSTERIA ARGENTEIN | Green/two |
| Saudi Arabic coffee | Saudi coffee mix (cardamom)/pH value of 5.64 (acidic) | Instant Saudi coffee, cardamom, cloves, nondaily coffee creamer, and saffron; used as hot coffee | Baja Food Industrial Co., Ltd. Jeddah, Saudi Arabia | Yellowish/two |
| NESCAFE | Nescafe, 3 in 1 (STRONG)/pH value of 5.96 (Acidic) | Sugar, glucose syrup, instant coffee (11%), palm kernel oil, soluble fiber, skimmed MILK powder (0.7%), MILK protein, salt, stabilizers, lactose (MILK), acidity regulator, emulsifiers, natural flavorings, MILK fat, and color | Nescafe, Saudi Arabia | Black/two |
| Artificial synthesis saliva | Unstimulated whole human saliva (pooled and filtered)/pH value of 5.27 (alkaline) | ≈99% water; electrolytes Na+~80 mmol L−1, K+~8 mmol L−1, Cl−~40 mmol L−1, HCO3− 15–25 mmol L−1, Ca2+~1–2 mmol L−1; proteins ≈ 0.5 g L−1 (amylase, mucins, proline-rich proteins, IgA, statherin); pH 6.2–7.6 | BiochemazoneTM Arab Science Trading Co., Ltd. Riyadh, Saudi Arabia | Clear, slightly opalescent/two |
| DZRT | DZRT® nicotine pouch, e.g., ‘Highland Berries 6 mg’/pH value of 7.42 (alkaline) | Cellulose plant fibers, water, pharma-grade nicotine 3/6/10 mg pouch−1, propylene glycol (humectant), sodium carbonate + bicarbonate (pH adjusters), acesulfame K or xylitol (sweeteners), food-grade flavorings, and trace NaCl | Badael International Co., Ltd. Riyadh, Saudi Arabia | White pouch/two (placed on specimens two times per day, for 30 min each time) |
| Smokeless tobacco (Shamma) | Black Shamma/pH value of 8.54 (alkaline) | Largely manufactured by powdering tobacco along with ash, flavors, oils, calcium oxide, and black pepper | Purchased in a plastic package from the market | Black/two |
| Spectrophotometer | VITA Easyshade Compact version V | Device used to measure wavelength transmitted from one object at a time, without being affected by subjective perceptions of color | VITA Zahnfabrik H. Rauter GmbH & Co. KG, Bad Sackingen, Germany | Measure the color parameters L, a, and b |
| Surface roughness tester | Profilometer | Device used to graphically record the average height of the profile above and below a center line along a given length of the sample | Perthometer M2, Mahr GmbH, Germany | Measure Ra |
| Scanning electron microscope | SEM | Device that uses a focused beam of electrons to scan the surface of a specimen and generate images at a much greater resolution than optical microscopy | East Sussex, BN8 6BN, UK | Measure the surfaces of samples |
| Bacterial adhesion | Bacterial colony-unit counting | Device for measuring Streptococcus mutans colony-forming units (CFU/mm2) | Fisher Scientific, CL334, NH, USA | Bacterial CFU/ mm2 |
| Staining Medium | ΔL | Δa | Δb |
|---|---|---|---|
| Mean | Mean | Mean | |
| Mirinda Citrus | −1.846 | 0.563 | −1.457 |
| CodeRed | −1.948 | 0.643 | −1.932 |
| Yerba mate tea | −2.031 | 0.621 | −1.731 |
| Saudi coffee | −2.113 | 0.643 | −1.598 |
| Nescafe | −2.147 | 0.743 | −2.012 |
| DZRT | −0.154 | 0.642 | 2.653 |
| Artificial saliva | 0.103 | 0.432 | −1.212 |
| Smokeless tobacco | −0.234 | 0.546 | 3.652 |
| Staining Medium | Mean Color Change (±SD) | p-Value | Mean Surface Roughness (±SD) | p-Value | Mean Bacterial Adhesion (±SD) | p-Value |
|---|---|---|---|---|---|---|
| Mirinda Citrus | 4.56 (±3.77) | <0.001 * | 0.566 (±0.039) | <0.001 | 510.92 (±35.95) | <0.001 |
| CodeRed | 4.47 (±3.31) | 0.489 (±0.025) | 546.75 (±28.63) | |||
| Yerba mate tea | 3.61 (±2.60) | 0.514 (±0.041) | 409.00 (±29.27) | |||
| Saudi coffee | 3.52 (±3.49) | 0.587 (±0.019) | 390.83 (±17.27) | |||
| Nescafe | 4.76 (±1.52) | 0.486 (±0.053) | 382.58 (±37.18) | |||
| DZRT | 6.46 (±4.76) | 0.748 (±0.092) | 372.17 (±20.43) | |||
| Artificial saliva (control) | 2.15 (±2.66) | 0.503 (±0.018) | 306.33 (±37.34) | |||
| Smokeless tobacco | 6.84 (±2.71) | 0.505 (±0.028) | 283.92 (±35.29) |
| Pair of Staining Media | Mean Color Change (Unit) | Surface Roughness (µm) | Bacterial Adhesion (CFU/mm2) | |||
|---|---|---|---|---|---|---|
| Difference | p-Value | Difference | p-Value | Difference | p-Value | |
| Mirinda Citrus vs. CodeRed | 0.09 | 0.997 | 0.077 | 0.002 | −35.83 | 0.101 |
| Mirinda Citrus vs. yerba mate tea | 0.95 | 0.815 | −0.052 | 0.108 | −101.92 | <0.001 * |
| Mirinda Citrus vs. Saudi coffee | 1.04 | 0.937 | 0.020 | 0.954 | −120.08 | <0.001 * |
| Mirinda Citrus vs. Nescafe | −0.20 | 1.000 | 0.080 | 0.001 | 128.33 | <0.001 * |
| Mirinda Citrus vs. artificial saliva (control) | 2.41 | 0.173 | 0.063 | 0.022 | 204.58 | <0.001 * |
| Mirinda Citrus vs. DZRT | −1.90 | 0.073 | 0.182 | <0.001 | −138.75 | <0.001 * |
| Mirinda Citrus vs. smokeless tobacco | −2.28 | 0.216 | −0.062 | 0.028 | −227.00 | <0.001 * |
| CodeRed vs. yerba mate tea | 0.86 | 0.382 | 0.025 | 0.882 | −137.75 | <0.001 * |
| CodeRed vs. Saudi coffee | 0.95 | 0.582 | 0.097 | <0.001 | −155.92 | <0.001 * |
| CodeRed vs. Nescafe | −0.29 | 0.999 | 0.003 | 1.000 | 164.17 | <0.001 * |
| CodeRed vs. artificial saliva (control) | 2.32 | 0.031 | −0.014 | 0.996 | 240.42 | <0.001 * |
| CodeRed vs. DZRT | −1.99 | 0.320 | 0.258 | <0.001 | −174.58 | <0.001 * |
| CodeRed vs. smokeless tobacco | −2.37 | 0.623 | 0.015 | 0.991 | −262.83 | <0.001 * |
| Yerba mate tea vs. Saudi coffee | 0.09 | 1.000 | −0.073 | 0.004 | 18.17 | 0.839 |
| Yerba mate tea vs. Nescafe | −1.15 | 0.732 | 0.028 | 0.802 | 26.42 | 0.433 |
| Yerba mate tea vs. artificial saliva (control) | 1.46 | 0.953 | 0.011 | 0.999 | 102.67 | <0.001 * |
| Yerba mate tea vs. DZRT | −2.84 | 0.001 | 0.234 | <0.001 | −36.83 | 0.083 |
| Yerba mate tea vs. smokeless tobacco | −3.23 | 0.004 | −0.009 | 1.000 | −125.08 | <0.001 * |
| Saudi coffee vs. Nescafe | −1.24 | 0.888 | 0.101 | <0.001 | 8.25 | 0.998 |
| Saudi coffee vs. artificial saliva (control) | 1.37 | 0.847 | 0.084 | 0.001 | 84.50 | <0.001 * |
| Saudi coffee vs. DZRT | −3.12 | 0.002 | 0.161 | <0.001 | −18.67 | 0.819 |
| Saudi coffee vs. smokeless tobacco | −3.32 | 0.010 | −0.082 | 0.001 | −106.92 | <0.001 * |
| Nescafe vs. artificial saliva (control) | 2.61 | 0.125 | −0.017 | 0.985 | 76.25 | <0.001 * |
| Nescafe vs. DZRT | −1.7 | 0.105 | 0.262 | <0.001 | −10.42 | 0.991 |
| Nescafe vs. smokeless tobacco | −2.08 | 0.286 | 0.019 | 0.974 | −98.67 | <0.001 * |
| Artificial saliva vs. DZRT | 4.31 | <0.001 | 0.245 | <0.001 | 65.83 | <0.001 * |
| Artificial saliva vs. smokeless tobacco | −4.69 | <0.001 | 0.002 | 1.000 | −22.42 | 0.642 |
| DZRT vs. smokeless tobacco | −0.38 | 1.000 | 0.243 | <0.001 | 88.25 | <0.001 * |
Disclaimer/Publisher’s Note: The statements, opinions and data contained in all publications are solely those of the individual author(s) and contributor(s) and not of MDPI and/or the editor(s). MDPI and/or the editor(s) disclaim responsibility for any injury to people or property resulting from any ideas, methods, instructions or products referred to in the content. |
© 2025 by the author. Licensee MDPI, Basel, Switzerland. This article is an open access article distributed under the terms and conditions of the Creative Commons Attribution (CC BY) license (https://creativecommons.org/licenses/by/4.0/).
Share and Cite
Alahmari, N.M. Comparative Analysis of the Effects of Acidic and Alkaline Beverages on the Optical Properties, Surface Topography, and Bacterial Activity of Zirconia Materials. J. Funct. Biomater. 2025, 16, 329. https://doi.org/10.3390/jfb16090329
Alahmari NM. Comparative Analysis of the Effects of Acidic and Alkaline Beverages on the Optical Properties, Surface Topography, and Bacterial Activity of Zirconia Materials. Journal of Functional Biomaterials. 2025; 16(9):329. https://doi.org/10.3390/jfb16090329
Chicago/Turabian StyleAlahmari, Nasser M. 2025. "Comparative Analysis of the Effects of Acidic and Alkaline Beverages on the Optical Properties, Surface Topography, and Bacterial Activity of Zirconia Materials" Journal of Functional Biomaterials 16, no. 9: 329. https://doi.org/10.3390/jfb16090329
APA StyleAlahmari, N. M. (2025). Comparative Analysis of the Effects of Acidic and Alkaline Beverages on the Optical Properties, Surface Topography, and Bacterial Activity of Zirconia Materials. Journal of Functional Biomaterials, 16(9), 329. https://doi.org/10.3390/jfb16090329
